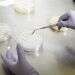
עיבוד דגימות  מזון במעבדה של Calyxt. צילום: Tim Gruber for The Washington Post צילום: Tim Gruber for The Washington Post

סגנית השליח האמריקני למזרח התיכון, מורגן אורטאגוס, אמרה בראיון ששודר ביום ראשון כי חיזבאללה וקבוצות חמושות אחרות צריכות להתפרק מנשקן "בהקדם האפשרי" וכי מצופה מהכוחות הלבנוניים לבצע את העבודה.
אורטאגוס דיברה עם השדרן הלבנוני LBCI בסיום ביקור של שלושה ימים בביירות, שם נפגשה עם נשיא לבנון ג'וזף עאון, ראש הממשלה נאוואף סלאם, יו"ר הפרלמנט נביה ברי ועם בכירים ונציגים פוליטיים אחרים.
הביקור שלה חל לאחר כמה שבועות של תקיפות אוויריות מצד ישראל לשטחי לבנון, שכוונו לעבר חברי חיזבאללה הנתמכים בידי איראן ולמחסני הנשק של הארגון, כולל שתי תקיפות בפרברים הדרומיים של ביירות, וכן אחרי ירי רקטות מלבנון לעבר ישראל, שחיזבאללה הכחיש כל מעורבות בו.
חילופי האש העמידו במבחן את הפסקת האש שכבר הייתה רעועה מלכתחילה, שקיוותה להביא לסיום מלחמה שנמשכה שנה בין ישראל לחיזבאללה. הפסקת האש באה עם קריאות לפירוק קבוצות חמושות ברחבי המדינה.
"זה ברור שחיזבאללה חייב להתפרק מנשקו, וברור שישראל לא הולכת לקבל מצב שבו יורים עליה טרוריסטים, לתוך המדינה שלהם, וזו עמדה שאנחנו מבינים", אמרה אורטאגוס. "אנחנו ממשיכים ללחוץ על הממשלה הזו למלא באופן מלא את הפסקת פעולות האיבה, וזה כולל את פירוק חיזבאללה וכל המיליציות מנשקן", היא הוסיפה.
כאשר נשאלה האם ארה"ב קבעה לוח זמנים לפירוק הנשק, אמרה אורטאגוס: "בהקדם האפשרי", ופירטה – "אין בהכרח לוח זמנים מה שנקרא, אבל אנחנו יודעים שככל שצבא לבנון (LAF) יוכל לעמוד ביעדים האלה ולפרק את כל המיליציות במדינה מוקדם יותר, כך יוכלו אזרחי לבנון להיות חופשיים מוקדם יותר".
הסכם הפסקת האש קורא לכוחות הלבנוניים לפרק עמדות צבאיות של קבוצות חמושות ולהחרים נשק בלתי מורשה, "בתחילה בדרום לבנון". הצבא השמיד מאות מחסני נשק בדרום לבנון מאז שההסכם נחתם בנובמבר, כך מסרו מקורות ביטחוניים לרויטרס.
חיזבאללה דוחה זה זמן רב ניסיונות לפרוק אותו מנשקו. הוא טוען שהפסקת האש חלה אך ורק על דרום לבנון, ולא על כלל המדינה, ומצביע על תקיפות האוויר הישראליות והנוכחות המתמשכת של ישראל בחמש עמדות הרריות בדרום לבנון כהפרות חמורות של הפסקת האש.